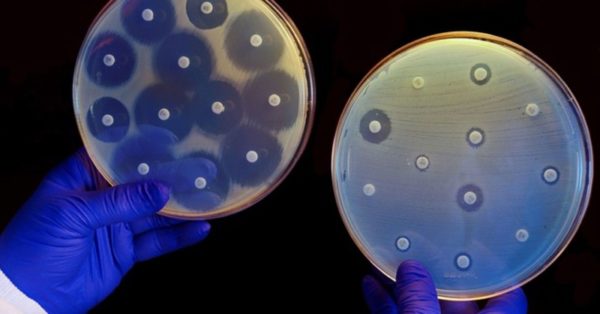
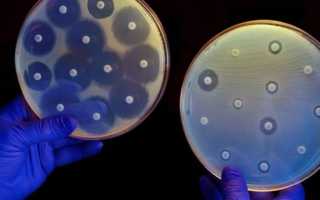

Стафилококки распространены в почве, воздухе, на предметах обихода и в организме человека. Различают патогенные, непатогенные и условно-патогенные типы микроорганизма. Staphylococcus Aureus считается одной из наиболее опасных форм бактерии, способной вызывать серьезные патологии в человеческом организме. Стафилококк ауреус отличается высокой резистентностью к антибиотикам и антисептическим растворам.
Особенности микроорганизма
- Стафилококки представляют собой бактерии округлой формы диаметром от 0,6 до 1,2 мкм. Микроорганизм вырабатывает пигмент желтого либо золотого оттенка, что обеспечивает специфическую окраску его колоний.
- Бактерия обладает высокой устойчивостью к факторам внешней среды и антисептическим растворам: выдерживает замораживание, 10-минутное кипячение, этиловый спирт, перекись водорода. Стафилококк может образовывать микрокапсулу до 0,2 мкр в диаметре при неблагоприятных условиях.
- Микроорганизм синтезирует ферменты, обеспечивающие ему дополнительную защиту:
- Лидаза и пенициллиназа обезвреживают антибиотики пенициллинового ряда и способствуют гнойному расплавлению кожи и слизистых оболочек.
- Коагулаза, прикрепленная к стенке бактерии, образует защитную оболочку из свернувшейся крови, что защищает ее от фагоцитов. Свободная форма фермента способствует возникновению тромбоза за счет формирования коагулазотромбина.
- Стафилококк продуцирует эндотоксин, вызывающий сильный интоксикационный синдром. Прогрессирование болезни нередко приводит к инфекционно-токсическому шоку и смерти.
- Имеют высокую резистентность (устойчивость) к различным группам антибиотиков (пенициллины, цефалоспорины).
Локализация
Золотистый стафилококк выявляется у пациентов с клиническими признаками заболевания и у здоровых людей. В 70-80% случаев возбудитель обнаруживают в носу. Однако микроорганизм может локализоваться в гортани, подмышечных впадинах, области промежности, желудочно-кишечном тракте, на коже.
Постоянными носителями стафилококка становятся треть медицинских работников, наркозависимые больные и лица, страдающие дерматитами атопического характера.
Группы риска
- Пациенты с ослабленной иммунной системой по причине болезни либо длительного лечения.
- Больные с нелеченными хроническими патологиями инфекционно-воспалительной природы (хронический тонзиллит, насморк, кариес, пародонтит).
- Недоношенные дети и груднички, получающие искусственное вскармливание.
- Лица, нарушающие принципы правильного питания и потребляющие некачественную пищу.
Как происходит заражение?
Источники инфекции:
- больные люди;
- носители без клинических проявлений;
- зараженные пищевые продукты;
- предметы обихода.
Пути инфицирования:
- воздушно-капельный;
- контактный;
- алиментарный (пищевой);
- вертикальный (от матери к ребенку).
Важным моментом в распространении инфекции является инфицирование в условиях лечебного учреждения, так как такие возбудители обладают наибольшей устойчивостью к антибактериальным препаратам.
Клиническая картина
Основными признаками инфицирования стафилококком являются:
- выраженный интоксикационный синдром (головокружение, выраженная слабость, понижение уровня артериального давления, тошнота);
- лихорадка до 39 градусов.
В зависимости от локализации очага поражения симптомы болезни могут варьироваться.
| Локализация инфекции | Болезни | Симптомы |
| Кожные покровы | Фурункул, флегмона, панариций, стафилодермия, импетиго, эпидемическая пузырчатка | Возникновение болезненного ограниченного участка гнойного воспаления либо мелких элементов сыпи с гнойным отделяемым |
| Лимфатическая система | Лимфаденит | Боль и отечность в области больного лимфоузла |
| Дыхательная система | Ринит, бронхит, пневмония, плеврит | Насморк, кашель с отхождением гнойной мокроты, одышка, боль в горле |
| Глаза | Конъюнктивит, язвы роговицы | Слезотечение, светобоязнь, отечность век, гнойное отделяемое из глаз |
| Пищеварительный тракт | Пищевые отравления (острый энтероколит) | Рвота (неоднократная), тошнота, послабление стула, изменение цвета кала |
| Опорно-двигательная система | Остеомиелит, артрит, миозит | Боль в области пораженных мышц, суставов, костей |
| Мочеполовая система | Цистит, уретрит, пиелонефрит, простатит | Болезненное, частое мочеиспускание, боли в пояснице либо внизу живота |
| Центральная нервная система | Менингит, абсцесс головного мозга | Головные боли, сыпь по коже, рвота фонтаном, эписиндром, положительные менингеальные симптомы |
Прогрессирование болезни ведет к развитию сепсиса. Распространение инфекции приводит к возникновению гнойных очагов по всему организму. Наиболее опасными осложнениями инфекции являются сепсис, менингит, инфекционно-токсический шок.
Диагностика
Диагностические мероприятия при стафилококковой инфекции направлены на:
- выявление возбудителя болезни и определение его типа;
- определение степени поражения и локализации очага;
- установление чувствительности бактерии к антибактериальным препаратам.
Бактериологическое исследование
Для исследования берут образцы крови, мочи, ликвора, гноя из раны, мокроты. Мазки, полученные из биоматериала, подлежат микроскопическому исследованию. Изучаются характеристики и свойства бактерий в нефиксированном (живом) и фиксированном (мертвом) виде.
Морфологическими признаками золотистого стафилококка считаются:
- округлая форма бактерии;
- скопление микроорганизмов в виде гроздьев;
- желто-золотистый цвет колоний.
Посев материала позволяет определить тип бактерии и установить ее чувствительность к антибиотикам.
Положительный тест на свободную коагулазу в крови подтверждает инфицирование золотистым стафилококком.
Серологические методы диагностики
Применяются в случае неэффективности бактериологического исследования. Методы позволяют выявить антигены стафилококка в плазме крови. Используются иммуноферментный анализ, ПЦР-диагностика, РНГА, РА.
Изучение массивности поражения
Данный показатель определяется путем посева биоматериала на питательные среды, изучения количества колоний и подсчета колониеобразующих единиц (КОЕ). О высокой степени заражения свидетельствует КОЕ более 5*106.
Лечебная тактика
- Антибиотики широкого спектра действия. Подбор препарата проводится с учетом результатов посева материала и определения чувствительности бактерии к антибактериальным препаратам.
Часто выбор останавливают на бета-лактамных препаратах (оксациллин, метициллин), иногда цефалоспоринах 1,2 поколения, тетрациклинах. В случае повышенной устойчивости к метициллину применяются фторхинолоны, ванкомицин, полусинтетические пенициллины, цефалоспорины 3,4 поколений.
Местные поражения кожи стафилококком лечат соответствующими антибактериальными мазями. При пневмонии или менингоэнцефалите показано лечение двумя антибиотиками.
- Иммуностимуляторы. Тяжелые клинические ситуации требуют дополнительного назначения иммуноглобулинов, противостафилококковой плазмы, бактериофагов, анатоксина.
- Дезинтоксикационная терапия. По показаниям назначается промывание желудка, капельницы с глюкозой, физраствором, Регидрон.
- Симптоматическое лечение. Учитывая область поражения стафилококком, врач может назначить отхаркивающие, противогрибковые препараты, средства для местного применения, пробиотики, пребиотики.
- Хирургическое вмешательство. При выявлении ограниченного гнойного очага применяется оперативное лечение.
Всегда ли нужны антибиотики?
При наличии выраженных клинических проявлений антибиотики нужны. Если инфекция клинически не проявляется, специалисты основываются на показатель КОЕ:
- 103 – проводится санация носоглотки, так как возможно активное распространение инфекции в окружающую среду;
- 104 – показаны антибактериальные препараты в сочетании с иммуностимуляторами;
- 105 – требуется серьезный комплексный подход к лечению.
При выраженных симптомах гнойного поражения кожи у взрослого и ребенка врачи не исключают золотистый стафилококк, который требуется в срочном порядке лечить. Эта опасная инфекция может стать основной причиной многих заболеваний внутренних органов и систем. При возникновении главного вопроса, как избавиться от золотистого стафилококка, требуется обратиться к компетентному специалисту. В противном случае в патологический процесс будет вовлечено все больше и больше здоровых тканей.
Что такое золотистый стафилококк
Эта простая инфекция золотистого цвета может спровоцировать такие опасные заболевания, как фурункулез, сепсис, пневмония, ангина, менингит, абсцесс, панариций, тонзиллит, остеомиелит. Локализуется микроб на слизистых оболочках и верхнем слое эпидермиса, способна проникать глубоко в здоровые ткани. Вылечить золотистый стафилококк непросто, поскольку патогенный микроорганизм устойчив к воздействию факторов окружающей среды, действию антибактериальных препаратов. Лечение воспалительных заболеваний с участием стафилококка требует комплексного подхода.
При возникновении гнойных воспалений необходимо сдать анализы на стафилококк золотистый. Возникновение такой инфекции в организме возможно в детском и взрослом возрасте, при воспалении оболочек явно не обойтись без дополнительного приема антибиотиков. Микробы выделяют токсины, тем самым вызывают воспаление. Организм страдает от симптомов острой интоксикации, причем такое состояние по мере роста патогенной флоры стремительно прогрессирует.
Как передается
Если стафилококк из носоглотки с током крови проникает в легкие, стремительно развивается пневмония. Чтобы исключить появление гнойных очагов, требуется заранее выяснить, как передается опасная инфекция к здоровому организму. Путей передачи микроба несколько – оральный, воздушно-капельный или контактно-бытовой. Чаще предшествует рецидиву ослабленный иммунитет, длительное заболевание с приемом сильнодействующих медикаментов. Микробы проникают разными путями, поэтому задача родителей – ответственно относиться к своему здоровью и здоровью собственных детей.
Симптомы
Лечащий врач подробно рассказывает, как может выглядеть стадия рецидива стафилококком. Симптомы повышенной активности шаровидных бактерий полностью зависят от предполагаемого очаг патологии, пугают своей интенсивностью. Патогенные микробы вырабатывают ферменты, которые являются причиной многочисленных гнойных воспалений. Выявить очаг патологии можно клиническим и лабораторным путем, а наталкивают на мысли о серьезном заболевании следующие симптомы:
- При поражении кожи наблюдаются обширные пятна в кожных складках и мелкая сыпь (псевдофурункулез), пузырьки с жидкостью (везикулопустулез), открытые раны подобно ожогам (болезнь Риттера), полость с гнойными массами (абсцесс) и нарушение подкожной клетчатки (флегмона).
- Стафилококковая инфекция в горле способствует развитию гнойной ангины, ларингита и фарингита. Больной жалуется на сухость слизистой оболочки и острый приступ боли при глотании, который при отсутствии мер своевременного реагирования только усиливается. Дополнительно присутствует высокая температура тела, можно выявить видимое воспаление миндалин.
- Заболевания дыхательных путей сопровождаются присутствием патогенных бактерий в носу. Сразу нарушается привычное дыхание, наблюдается заложенность, сухой приступообразный кашель. Ринит с отделением гной – первый признак, как проявляет себя стафилококк ауреус в носу.
- Когда стафилококк продуцирует во рту, очагом поражения становится слизистая оболочка ротовой полости. В ее структуре появляются болезненные язвочки, и при размножении бактерий клиническая картина усугубляется. Стафилококк сразу поражает слизистые, поэтому на такой признак недуга требуется обратить внимание первым.
- При поражении глаз развивается острый конъюнктивит, дополненный повышенной отечностью и болезненностью век, слезотечением, светобоязнью. К серьезным осложнениям стафилококковой инфекции в такой клинической картине можно отнести резкую посадку зрения, спазм аккомодации.
- Если стафилококк золотистый поражает систему мочевыводящих путей, пациент жалуется на учащенное мочеиспускание, болезненность при походах в туалет, боль в пояснице, появление примесей крови в биологической жидкости. Как вариант, развиваются пиелонефрит, цистит или уретрит с острой симптоматикой.
- При поражении ЦНС у пациента резко повышается температура тела, наблюдаются выраженные признаки интоксикации организма. Среди таковых приступы рвоты, частичное обезвоживание, кожная сыпь и приступы мигрени. Как осложнение, врачи выделяют прогрессирующий менингит и абсцесс головного мозга.
У взрослых
Наличие очаговой инфекции кожных покровов требуется своевременно лечить, иначе дерма меняет свою структуру, а патологический процесс перекидывается на здоровые органы, системы. Общими симптомами интоксикации являются выраженные признаки диспепсии, рвота, сильные приступы мигрени, кожные высыпания и высокая температура. Присутствие кожных инфекций дополняется гиперемией верхнего слоя эпидермиса, зудом и отечностью. Если наблюдается внутреннее заражение и распространение инфекции, клиническая картина осложняется, требует немедленного врачебного участия.
Симптомы у детей
Инфицирование при аномальной работе иммунной системы сопровождается высокой температурой тела, нарушением микрофлоры кишечника и общими признаками отравления организма. При устойчивом иммунитете носительство золотистого стафилококка бессимптомное. О локализации патогенной флоры пациент и его родители могут не догадываться, а узнают случайно – при плановой диспансеризации.
Причины возникновения
Частыми возбудителями опасных болезней в детском и взрослом возрасте становятся стафилококки золотистые, которые в большинстве случаев поражают слизистую носоглотки, кожные покровы. Прежде чем лечить характерный недуг, важно выявить этиологию патологического процесса. Крайне нежелательному проникновению золотистого стафилококка предшествуют следующие патогенные факторы:
- нарушение правил личной гигиены;
- проникновение инфекции при пищевых отравлениях (некачественные продукты питания);
- не соблюдение правил асептики при работе с медицинским инструментом;
- нанесение на тело пирсингов и татуировок;
- дисбактериоз;
- ослабленный иммунитет;
- результат попадания инфекции из окружающей среды;
- при поражениях кожных покровов термического или механического происхождения;
- использование специальных аппаратов для внутренней установки.
Диагностика
Провоцирует воспаление характерный микроб при ослаблении иммунной системы, однако обнаружить золотистый стафилококк можно только лабораторными методами. Справиться с патогенными возбудителями помогут следующие мероприятия, реализованные в условиях стационара:
- стандартный коагулазный тест в пробирке;
- латекс-агглютинация;
- общие анализы крови, мочи, кала;
- реакция агглютинации Видаля;
- посев биологического материала;
- биохимический анализ крови;
- мазок с века при подозрении на конъюнктивит.
Посев на золотистый стафилококк
Биологическим материалом чаще становится мазок из носа или зева для лабораторного исследования. Борется он у взрослых пациентов или грудничка при подозрении на присутствие в организме штаммов золотистых. После этого врач определенный временной интервал наблюдает за естественным ростом патогенной флоры (при наличии таковой) в лабораторных условиях, максимально приближенным к естественным. Если бактерии на протяжении указанного периода не обнаружены, это норма, и пациент считается здоровым. Характерными проявлениями заболевание сначала диагностируют, а потом лечат.
Лечение
Распространение признаков заболевания требуется своевременно лечить преимущественно консервативными методами. Токсические микробы способны вырабатывать устойчивость иммунитета к антибиотикам, поэтому требуется комплексный подход к проблеме со здоровьем, включающий сразу несколько фармакологических групп. Преодолеть устойчивых штаммов помогут следующие медикаменты:
- стафилококковый анатоксин;
- бактериофаги;
- антистафилококковый иммуноглобулин;
- лизаты бактерий;
- стафилококковая вакцина;
- препараты алоэ;
- иммуноглобулиновый препарат;
- раствор хлорфиллипта.
Пораженную оболочку носоглотки рекомендуется обрабатывать лечебными мазями с антибиотиками мупироцин. Уместно такое фармакологическое назначение при кожных заболеваниях, фурункулах, стафилококковом сепсисе. При тяжелой степени характерного недуга такие местные лекарства отличаются низкой эффективностью, посредственным действием. При хронической инфекции уместны следующие медицинские препараты для использования наружно: Левомеколь, Банеоцин, метилурациловая мазь.
Лекарство
Стафилококк золотистый способен поражать новорожденных, поэтому симптоматическое лечение маленького ребенка должно проводиться своевременно. Первым делом требуется определить, где стафилококки обитают, каковы особенности патологического процесса, а затем индивидуально определять особенности интенсивной терапии. Чтобы лечение золотистого стафилококка было максимально продуктивным, эффективные лекарства от острых и хронических заболеваний представлены ниже.
Бактериофаг
Это фармакологические средства с вирусами, способными поражать стафилококк. После проникновения в организм снижают устойчивость патогенной флоры. Собраны вирусы в состав медицинских препаратов, например, хорошо зарекомендовал себя бактериофаг стафилококковый, выпускаемый в форме раствора, свечей, мази или таблеток для применения перорально. В пораженном организме демонстрирует устойчивый антибактериальный эффект, продуктивно истребляет эпидермальных стафилококков.
Антибиотики
Бактерии staphylococcus aureus можно уничтожить правильно подобранными антибиотиками. Такое фармакологическое назначение не должно быть самовольным, особенно если речь идет о здоровье ребенка. В противном случае, среди потенциальных осложнений врачи выделяют пневмонию легких, абсцесс головного мозга, стафилококковый сепсис и другие смертельные диагнозы. Если обнаружен в организме стафилококк aureus, для пациента в любом возрасте не должно становиться шоком назначение антибактериальной терапии. Это:
- Амоксиклав – представитель группы пенициллинов, к которому стафилококки демонстрируют особую чувствительность. Принимать внутрь показано по 1 таблетке 3 раза в сутки на протяжении 7-10 дней.
- Метициллин, Оксациллин – представители полусинтетических пенициллинов, предназначены для применения перорально на протяжении 7 суток, согласно инструкции.
- Кларитромицин — полусинтетический антибиотик-макролид широкого спектра действия. Принимать по 1 капсуле дважды за сутки.
- Ванкомицин – трициклический антибиотик из группы гликопептидов, терапевтический эффект которого обеспечен ингибированием биосинтеза клеточной стенки стафилококка.
- Линкомицин – представитель группы линкомицинов, который выпускается в форме горького белого порошка, принимать внутрь на протяжении 5-7 суток.
Последствия
Особенно опасен характерный микроб для подрастающего поколения, грудных детей. Иммунитет ребенка ослаблен, а среди потенциальных осложнений со здоровьем врачи выделяют следующие диагнозы:
- кома;
- инфекционно-токсический шок;
- летальный исход;
- сепсис;
- менингит.
Прогноз и профилактика
Клинический исход полностью зависит от тяжести характерного недуга, требует своевременного реагирования пациента на начальную симптоматику. На ранней стадии болезнь можно окончательно вылечить, а на поздней – не исключена смерть клинического больного. Чтобы избежать опасного рецидива, важно всячески избегать контакта с зараженными людьми, тщательно соблюдать правила личной гигиены и придерживаться других мер профилактики. После перенесенной инфекции приобретенный иммунитет не формируется.
Стафилококки – это неподвижные, безъядерные, грамположительные бактерии, вызывающие у человека инфекционные заболевания. С медицинской точки зрения интерес представляют лишь несколько видов семейства Staphylococcaceae, к которым принадлежит и стафилококк ауреус.
Стафилококк, что это такое?
Микроорганизмы распространены повсеместно, в большом количестве содержатся в воздухе и почве, колонизируют кожу и внутренние органы животных.
Морфологически бактерии представляют собой шарики размером 0,6-1,2 мкм. Некоторые виды продуцируют окрашивающие пигменты. Колонии золотистого стафилококка имеют желтый или золотистый оттенок.
Патогенные и условно-патогенные стафилококки
Патогенные бактерии продуцируют агрессивные и защитные агенты — токсины, адгезины, ферменты.
Стафилококки составляют часть нормальной микрофлоры людей, заселяют различные области тела – кожные покровы, рот, носоглотку, промежность, подмышечную область, ЖКТ.
При нормальном иммунитете и отсутствии провоцирующих факторов бактерии не наносят вреда. Их активизация и переход в патогенное качество происходит при снижении иммунитета, повреждении кожи и слизистых оболочек при иных провоцирующих заболевание факторов.
Патогенность стафилококков основывается на 3-х свойствах:
- адгезивности (способность крепиться к клеткам организма);
- колонизации (размножение на тех средах, на которых они закрепились);
- инвазивности (проникновение в ткани и органы, продуцирование биологически активных агентов).
Оптимальная для жизнедеятельности стафилококка температура составляет 30-37 °C. Способность к росту и размножению сохраняется в интервале 4-43 °C, но бактерии могут выживать и в гораздо более суровых условиях.
Параметры экстремальных сред и время существования стафилококков
| Параметры среды | Время существования |
| Температура 60 °C | 1,0 час |
| Температура 80 °C | 30 минут (некоторыештаммы) |
| Температура 150 °C | 10 минут (некоторые штаммы) |
| Солнечное ультрафиолетовое излучение | 10-12 час |
| Раствор фенола (3%) | 0,15-2 час |
| Высушенное состояние | Около 6 месяцев |
| Гной | Несколько лет |
| 6-10% раствор поваренной соли | Длительное время |
| Раствор хлорамина (1%) | 2-5 минут |
| Этанол | Резистентность к чистому спирту |
Разновидности бактерии
Род стафилококков насчитывает 27 видов. Некоторые из них имеют по нескольку подвидов. Инфекции у людей вызывают всего пять микроорганизмов:
- Стафилококк золотистый (S. Aureus) — наиболее патогенный вид, вызывающий около 100 заболеваний.
- Эпидермальный стафилококк (S. Epidermidis) —присутствует в микрофлоре кожи многих здоровых людей.
- Staphylococcus lugdunensis – условно-патогенная бактерия, проявляющая свою патогенность в основном при имплантах.
- Стафилококк сапрофитный (S. Saprophyticus). Инфицирует преимущественно мочевые пути.
- Staphylococcus warneri. Локализуется обычно в пищеводе, заболевание вызывает редко, активизируется при наличии искусственных клапанов, внутривенных катетеров, вентрикулоцеребральных шунтов. Способен спровоцировать эндокардит, остеомиелит, конъюнктивит.
Важной особенностью стафилококков является синтез коагулазы – кровесвертывающего патогенного фермента. В зависимости от способности продуцировать плазмокоагулазу стафилококки подразделяются на коагулаза-отрицательные и коагулаза-положительные. Последние более патогенны.
Сапрофитный, lugdunensis, эпидермальный и warneri – коагулазонегативные стафилококки. Они часто колонизируют слизистые и кожу человека и обычно не вызывают заболеваний.
Особенности золотистого стафилококка
Staphylococcus Aureus – самый опасный вид стафилококка. Бактерия вызывает гнойно-воспалительные процессы в жизненно важных органах с развитием тяжелых осложнений, которые могут привести к смерти.
У здоровых людей (бактерионосителей) стафилококк обычно присутствует в полости носа (в 70-90 % случаев), реже в гортани, в подмышках, промежности (5-20 %), ЖКТ, на волосистой части головы.
Хроническими носителями стафилококка становятся работники медицинских учреждений (35 %), а также люди, страдающие атопическими дерматитами, наркоманы.
Наибольшее распространение имеют больничные штаммы S. Aureus. После госпитализации 20–30 % больных становятся их носителями. В большинстве случаев инфекция развивается в результате манипуляций, нарушающих целостность кожи, антибиотикотерапии, гемодиализа, лечения инсулинозависимого диабета.
Золотистый стафилококк способен формировать микрокапсулы — маленькие (0,2 мкр) круглые образования с четко ограниченным контуром. Капсулы прикреплены к стенке бактерий и защищают их от повреждений и высыхания.
Отдельные штаммы золотистого стафилококка (чаще всего больничные) приобретают резистентность к некоторым антибиотикам – цефалоспоринам и пенициллинам (Оксациллину, Метициллину, Нафциллину, Диклоксациллину). Их называют метициллин-резистентными (MRSA).
Пути передачи возбудителя
В качестве источников заражения золотистым стафилококком могут выступать:
- люди, больные стафилококковой инфекцией;
- бактерионосители;
- зараженная пища.
- контактным (через руки и вещи);
- воздушно-капельным (при разговоре, чихании, кашле);
- алиментарным (при приеме пищи, зараженной стафилококком);
- от матери к ребенку.
Важную роль в распространении стафилококковых заболеваний играют лечебные учреждения. Источниками больничных инфекций являются больные и бактерионосители среди медперсонала. Распространена передача бактерии через медицинские инструменты.
Стафилококковая инфекция
Способность поражать различные органы и ткани человеческого организма, которой отличается золотистый стафилококк, называется полиорганным тропизмом.
| Локализация | Заболевания |
| Кожа, подкожная клетчатка | Стафилодермия, фурункулы, карбункулы, пиодермия, панариции, паронихии, флегмоны, маститы, эпидемическая пузырчатка, импетиго |
| Лимфоузлы | Лимфадениты |
| Органы дыхания | Стафилококковые бронхиты, плевриты, пневмонии |
| Ларингооторинологические органы | Гаймориты, отиты, тонзиллиты, ангины |
| Гепатобилиарная система | Холангиты, холециститы |
| Глаза | Язвы на роговице, конъюнктивиты |
| Опорно-двигательная система | Миозиты, артриты, остеомиелиты |
| ЖКТ | Пищевые отравления |
| Мозг | Менингит, абсцессы |
| Мочеполовая система | Уретрит, пиелонефрит, гломерулонефрит, простатит, цистит и так далее |
Самые распространенные заболевания
Поражения кожи относятся к наиболее распространенным стафилококковым инфекциям. По частоте возникновения лидируют фурункулы, гнойничковые заболевания, карбункулы, пиодермия.
Пищевая инфекция (стафилококковый токсикоз). Болезнь развивается и проявляется стремительно – схваткообразными болями, тошнотой, рвотой, поносом – спустя 3-6 часов после приема инфицированной пищи. В большинстве случаев через 5-7 суток наступает самоизлечение.
Острая и хроническая пневмония. Острой форме стафилококковой пневмонии подвергаются 5-10 % всех больных воспалением легких.
Инфекция проявляется выраженной интоксикацией, одышкой, субфебрильной температурой с ознобами, кашлем с гнойной мокротой. Заболевание опасно плевральными осложнениями. В группу повышенного риска входят пожилые люди и дети раннего возраста.
Стафилококковый бронхит. Обычно начинается с инфицирование ВДП, затем болезнь распространяется на гортань, трахею и бронхи.
Остеомиелит. Возникает при заносе стафилококка в кости (обычно в поврежденные) с кровью или из соседнего очага инфекции. У взрослых чаще всего поражаются позвонки, у детей – трубчатые кости.
Менингит. Воспаление оболочки спинного и головного мозга с риском формирования абсцессов. Проявляется сильный головной болью, гиперестезией, нарушением сознания. Возможна кома. Наиболее типичным симптомом менингита является ригидность шеи (запрокидывание головы назад, и затруднение при возвращении ее в нормальное положение).
Общие симптомы
Общая симптоматика стафилококковых инфекций обуславливается интоксикацией организма с характерной клинической картиной.
- плохое самочувствие, физическая и умственная слабость;
- озноб, повышенная температура (до 39 °C);
- снижение аппетита, тошнота;
- Головная боль, головокружение;
- снижение АД;
- нарушение сна.
Болезнь способна переходить в генерализованные формы – септикопиемию или сепсис. Генерализация инфекции обуславливается распространением стафилококков по сосудистому руслу в органы – печень, легкие, кости, почки и другие, создавая там очаги инфекции. Болезни сопровождаются дискомфортом, болью, дисфункцией органов.
Тяжелые осложнения – менингит, отек мозга, сепсис могут вызывать потерю сознания и кому.